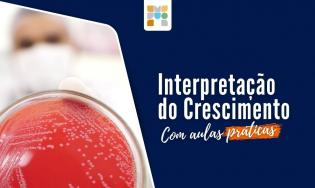

30 materiais
Assine agora
+ R$ 59,90 taxa de adesão
Sobre a Assinatura
O Microlab Academy é uma assinatura mensal, ideal para estudantes e profissionais na área da saúde, especialmente Análises Clínicas. Com esta assinatura você libera acesso a todos os nossos conteúdos interativos, passando a ter acesso a: todos os cursos de aprimoramento, treinamentos práticos online, workshops, e-books, workbooks, Podcasts exclusivos e muito mais. O Microlab Academy é completo, os conteúdos abordam profundamente os temas nas diferentes áreas das Análises Clínicas, como: bioquímica, parasitologia, uroanálise, biologia molecular, genética, hematologia, imunologia e sobretudo e com maior destaque a Microbiologia Clínica. Assinar o Microlab Academy te dará acesso a um certificado por curso concluído, baixar os PDFs dos conteúdos e muito mais.
Público alvo
Esta assinatura é ideal para estudantes de graduação e para profissionais que desejam se atualizar ou aperfeiçoar seus conhecimentos em microbiologia. Estudantes e profissionais das áreas de Biologia, Biotecnologia, Biomedicina, Bioquímica, Farmácia, Medicina, Medicina Veterinária, Zootecnia, Técnicos de Laboratório, Técnicos em Análises Clínicas e áreas afins.
Sobre o certificado
O certificado emitido pela Microlab Educacional refere-se a um curso livre profissional na área de interesse, com carga horária compatível com os padrões de qualificação técnica exigidos pelo Ministério da Educação. Este curso está devidamente amparado pela legislação educacional brasileira, que permite a oferta de cursos livres e de educação continuada por instituições legalmente constituídas. Nos termos do Art. 205 da Constituição Federal, da Lei de Diretrizes e Bases da Educação Nacional (Lei nº 9.394/1996) e do Decreto nº 5.154/2004, os cursos livres são enquadrados como educação profissional de nível básico ou como parte da educação continuada, não estando sujeitos à autorização ou reconhecimento prévio do Ministério da Educação (MEC).
Assim, os certificados de cursos livres possuem validade legal para fins de:
- Aprimoramento e qualificação profissional, incluindo área técnica e laboratorial;
- Comprovação de horas de atividades extracurriculares ou complementares;
- Pontuação em concursos públicos e processos seletivos, quando previsto em edital;
- Atualização de profissionais já habilitados ou em busca de conhecimento técnico especializado.
Reconhecimento do Certificado
O certificado do curso contém:
- Nome completo do aluno;
- Carga horária total cursada;
- Conteúdo programático abordado;
- Nome do curso e área de especialização;
- Assinatura digital ou eletrônica da coordenação e direção da instituição;
- Validação por QR Code, garantindo a veracidade e autenticidade do documento.
A Microlab Educacional é uma empresa registrada, especializada em ensino técnico, científico e pós-graduação e profissionalizante na área da saúde, e atua em conformidade com as normas da LGPD (Lei nº 13.709/2018), garantindo segurança e privacidade dos dados dos alunos.
Avaliações
Opinião dos alunos que se matricularam65 avaliações
R$ 59,90
era R$ 89,90 /mensal
- 1180 horas de carga horária
- 32 assinantes
- 257 aulas
- 57 módulos
- 30 cursos inclusos
- Última atualização 26/11/2025
- Certificado de conclusão de curso
- Garantia de devolução em até 7 dias
Entrar na lista
…
As matrículas para este curso esgotaram-se no momento. Inscreva-se abaixo para reservar o seu nome na próxima turma.
Cadastro de usuário
É necessário ter uma conta Microlab Educacional. Se você já é aluno, faça o login . Caso não seja, cadastre-se abaixo e comece já!
…
- Dentro de instantes você receberá um e-mail de confirmação do cadastro.
- Caso não encontre nosso e-mail em sua caixa de entrada, verifique a caixa de spam ou lixeira.
Obrigado!